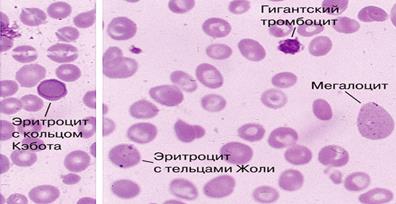

Главная страница Случайная страница
КАТЕГОРИИ:
АвтомобилиАстрономияБиологияГеографияДом и садДругие языкиДругоеИнформатикаИсторияКультураЛитератураЛогикаМатематикаМедицинаМеталлургияМеханикаОбразованиеОхрана трудаПедагогикаПолитикаПравоПсихологияРелигияРиторикаСоциологияСпортСтроительствоТехнологияТуризмФизикаФилософияФинансыХимияЧерчениеЭкологияЭкономикаЭлектроника
Экзаменационная задача №2. Больной поступил с жалобами на слабость, отсутствие аппетита, одышку при ходьбе, онемение пальцев рук.
|
|
Больной поступил с жалобами на слабость, отсутствие аппетита, одышку при ходьбе, онемение пальцев рук.
Ухудшение в течение полугода, когда заметил появление одышки, которая постепенно нарастала. В течение последних двух месяцев отмечает снижение аппетита, похудел на три килограмма. В это же время появилось онемение пальцев рук и парестезии.
Объективно: состояние средней тяжести. Кожные покровы и видимые слизистые бледные, склеры иктеричны. Периферические лимфатические узлы не увеличены. Пальпация грудины и ребер безболезненна. ЧДД 20-22 в 1 мин. В легких перкуторно – ясный легочный звук в симметричных участках легких, аускультативно – жесткое дыхание, хрипы не выслушиваются. АД – 125/70 мм рт.ст. Тоны сердца ритмичны, приглушены, выслушивается мягкий систолический шум над всеми точками аускультации. Пульс – 92 уд./мин., удовлетворительных качеств. Живот при пальпации мягкий, безболезненный, печень, селезенка пальпируются по краю реберной дуги.
При обследовании в общем анализе крови выявлено: Нв – 40 г/л, эритроциты – 1, 0х 1012/л, ЦП – 1, 25, лейкоциты – 2, 2х109/л, нейтрофилы палочкоядерные – 2%, сегментоядерные – 40%, лимфоциты – 57%, моноциты – 1%, тромбоциты – 70х109/л, гиперсегментация нейтрофилов.
Общий анализ мочи – прозрачная, плотность 1018, белок – не обнаружен, лейкоциты – 2-4 в п/зрения.
Биохимический анализ крови: билирубин – 30 мкМоль/л, АсАт - 28 ед/л, АлАт – 36 ед/л, глюкоза – 5, 6 мМ/л.
Рисунок к задаче № 2. Морфология эритроцитов периферической крови.
ВОПРОСЫ:
- Ваш диагноз
- Каковы причины развития заболевания?
- Дифференциальная диагностика с альтернативными заболеваниями.
- Дополнительные методы исследования, необходимые для подтверждения диагноза.
- Назначьте лечение.